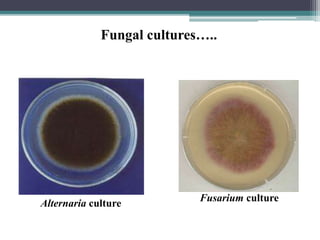
Alternaria culture
Fusarium culture
Fungal cultures…..

This document discusses advance portable tools for on-site detection of plant pathogens. It covers various disease detection tools including visual observation, cultural techniques, and the Foldscope microscope. It also discusses indirect detection methods like thermography, fluorescence imaging, hyperspectral techniques, and gas chromatography. Biosensor approaches for plant pathogen detection are also presented, including antibody-based biosensors, optical immunosensors, fluorescent approaches using quantum dots, and surface plasmon resonance systems. Loop mediated isothermal amplification is also discussed. The document emphasizes the importance of early detection of plant diseases and notes that most biosensors are still only used in labs, but more portable devices are expected in the future to support efficient disease diagnosis.

![THERMOGRAPHY
Thermography allows the visualization of differences in
surface temperature by detecting emitted infrared radiation
[long-wave infrared (8–14 mm)].
Airborne sensors are suitable for the detection of field
patches that are diseased with soilborne pathogens (Hillnutter
et al 2011) or in later stages of the diseases (Mahlein et al
2012).](https://image.slidesharecdn.com/detectionofplantpathogen-200311165408-230219153916-896a0cb9/85/detectionofplantpathogen-200311165408-pdf-14-320.jpg)





































